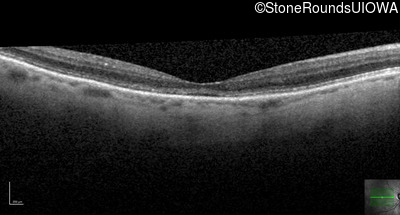
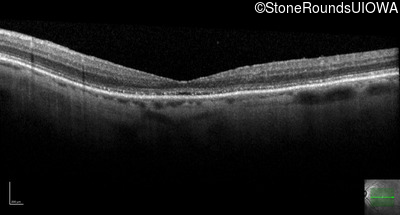
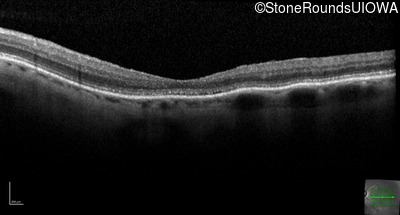
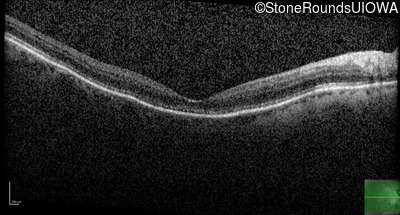
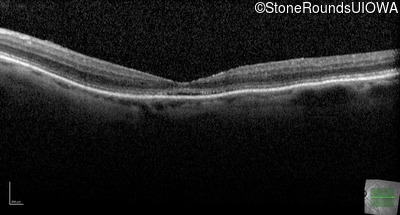
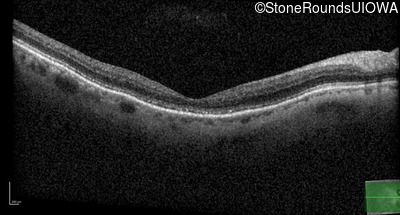
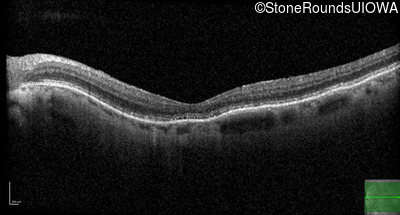
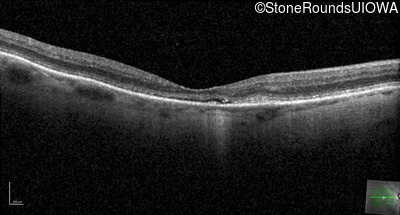
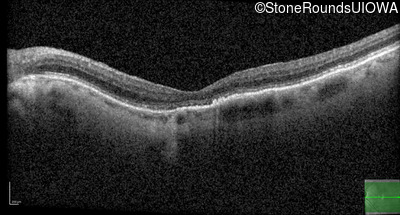

Case
SR869
Student Mode
Occult Macular Dystrophy (IIE)
Female
Female
Hidden
SR869
Student Mode
Occult Macular Dystrophy (IIE)
Female
Female
History
This 70 year old woman first noticed some reduction in visual acuity in both eyes at age 45. Her visual acuity had been previously normal.
| Color Vision: | Correctly identified 7/14 Ishihara pseudoisochromatic plates OU. |
|---|---|
| Refraction OD: | -1.75 +1.00 x 140 |
| Refraction OS: | -1.25 +0.50 x 20 |
Teaching Points
The clinical features favoring the diagnosis of RP1L1-associated occult macular dystrophy include: reduced acuity with a near-normal ophthalmoscopic appearance, a history of normal acuity in childhood; and, a "moth-eaten" appearance of the macular ellipsoid zone on OCT.
| Age at visit: 77 years |
| Age at visit: 79 years |
Diagnosis & molecular findings
| Disease | Gene | Allele 1 variant(s) | Allele 2 variant(s) | Inheritance mode |
|---|---|---|---|---|
| Occult Macular Dystrophy | RP1L1 | Arg45Trp CGG>TGG | AD |